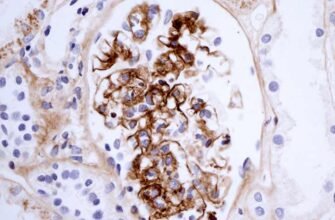
Хвороба Берже: симптоми, діагностика та сучасні методи лікування Хвороба Берже: симптоми, діагностика та сучасні методи лікування

Візілотон: тонус для Ваших очей
Кажуть, що очі — це дзеркало душі. А якщо дзеркало тьмяне? Візілотон може стати вашим рятівником. Отже, що це таке і як може допомогти? Чесно, навіть не знаю з чого почати. Ну, спробуємо, може? Призначають його при різних проблемах із зоровим сприйняттям. Це такі дивні ліки, правда. Краплі для очей — такі маленькі, такі цінні.
Від чого призначають Візілотон?
Очі потребують догляду і турботи. Ви задумувались, скільки значать ці наші оптичні органи? Вони наче мініатюрна лабораторія. Втім, часом трапляються збої. Саме тут на сцену виходить візілотон. Показання:
- Втома очей — всім знайома ситуація. Від роботи за комп’ютером до довготривалого читання.
- Синдром сухого ока — як у пустелі без дощу.
- Інші захворювання чи травми роговиці — небагато, але важкі.
Яка ще тут магія? Візілотон допомагає підтримувати ідеальний баланс вологи, забезпечуючи безпечне й комфортне середовище для вашого бачення.
Спосіб застосування та дози
Ну, знову-таки, важливо не переборщити. Всякий раз коли вам щось капнути в очі — це вже цікава справа. Я ж думаю, що не багато хто з нас любить цю процедуру. З візілотоном все просто, якщо ви дотримуєтесь інструкції.
- Зазвичай капати по 1-2 краплі в уражені очі.
- Повторяйте це 2-3 рази на день.
- І так, не забувайте струшувати флакон перед використанням!
І не треба тут усе спрощувати до банальщини. У вас є своє життя, свої очі, своє бачення цього всього. А раптом будь-який некомфорт — краще проконсультуйтесь з лікарем, так, на всяк випадок.
Механізм дії та переваги
Може, і не завжди це прозоро, але в медичному світі важлива річ — розуміння як і чому воно функціонує. Візілотон підтримує слизооболонку ока. Робить її зволоженою і захищеною. І дає їй, мабуть, нове дихання.
| Елемент | Дія |
|---|---|
| Зволожуючі компоненти | Покращують гідратацію очей |
| Захисний бар’єр | Захищає від агресивної дії зовнішніх факторів |
Звучить круто, правда? Наче казка для зору. Напівпрозоре „фільмування” на роговицю стає не надто помітним, але дуже ефективним. Така собі вуаль, що постійно захищає.
Перспективи та застосування
Не буду говорити стандартні речі. Всі ж ми знаємо, що допомагає, як той самий плед холодної зимою. Візілотон — він наче мастило в спричиненій втомою механізмі зору. Так, це досить практичний шлях, але можливості його куди більше.
До того ж, нинішній темп життя настільки шалений, що доводиться підлаштовуватись під численні стреси — а візілотон цілком може допомогти тримати „світло” в очах, буквально і метафорично.
Наслідки та застереження
У світі сучасної медицини завжди є місце для обережності. ‘Маленька дозировка’ — це так, як ключ до таємних дверей вашої зорової системи. Але й потрібно бути обережними — адже занадто багато доброго теж може бути погано, якось так.
- Не перевищуйте рекомендовану дозу.
- Якщо трапляється алергічна реакція — стоп!
- Завжди дотримуйтесь інструкцій.
ІNTAINAION така ось річ. Візілотон може бути вашим кращим другом, якщо ви будете дбаєте про свої очі.
Заключні думки
Візілотон — це невеликий, але потужний крок до покращення якості зору. В світі, що постійно змінюється, кожен з нас потребує підтримки, і ця підтримка може бути, як в вигляді краплі, так і в філософії — завжди піклуватись про деталі. В найменшому — найцінніше.
Так що варто задуматись: ось цей Візілотон, можливо, саме те, що ви шукали.